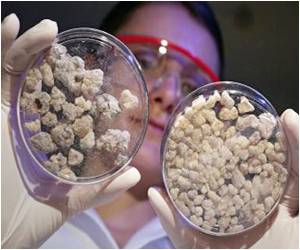
Frankincense as an Alternative Medicine

According to a recent research, children who see specialists for chronic medical conditions are also using complementary medicine at an increased rate.

"The children in this study are often given prescription medicines," says Vohra, a pediatrician who works in the Department of Pediatrics and the School of Public Health at the U of A."And many of these children used complementary therapies at the same time or instead of taking prescription medicine. We asked families if they would like to talk about the use of alternative medicine, more than 80 per cent of them said, ’yes, please.’ "Right now, these families are getting information about alternative medicine from friends, family and the Internet, but a key place they should be getting this information from is their doctor or another member of their health-care team, who would know about possible drug interactions with prescription medicines."Vohra said the study "identified a gap in communications" in dealing with pediatric patients and their families.
"It’s important to get these conversations going with every patient, especially when you consider it’s not widely recognized how common it is for children with chronic illnesses to use alternative medicine," says the Alberta Innovates-Health Solutions scholar. "We need to make sure these families are comfortable telling their specialists they are taking other therapies," she said.Right now, Vohra and her colleagues at the U of A have developed curricula for undergraduate medical students about the use of alternative medicine by pediatric patients, which is considered innovative and novel. Ensuring medical students receive information about alternative medicine is key because it arms them with more knowledge about potential interactions with prescription medicine, says Vohra."Considering parents are saying they want this information, we have an obligation to ensure future physicians have the education and resources they need for these conversations," Vohra says.
Source-Eurekalert
MEDINDIA

Email








